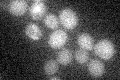
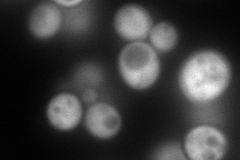
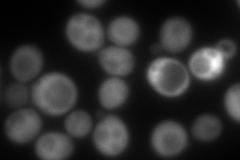
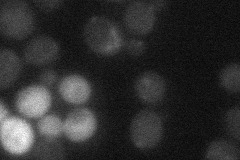
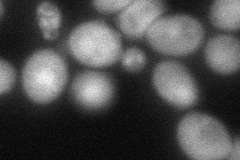

View description
Possible chaperone and cysteine protease with similarity to E. coli Hsp31; member of the DJ-1/ThiJ/PfpI superfamily, which includes human DJ-1 involved in Parkinson's disease; exists as a dimer and contains a putative metal-binding site
Localization:
Intensity:
Fold change:
Significance:
-
C’ GFP library in SD
below threshold16.16 -
N' NOP1pr-GFP in SD
cytosol261.27 -
N' TEF2pr-mCherry in SD
cytosol360.705 -
N' NATIVEpr-GFP in SD
below threshold19.9911 -
N' TEF2pr-VC and Cyto-VN in SD
cytosol,nucleus74.8771 -
C’ GFP library in SD+DTT

cytosol19.261.19No -
C’ GFP library in SD+H2O2

cytosol15.020.92No -
C’ GFP library in Starvation Media

cytosol16.461.01No -
C’ GFP library on the background of Pup2-DaMP

below threshold -
C’ GFP library on the background of CCT mutant

below threshold15.93620.985699No
